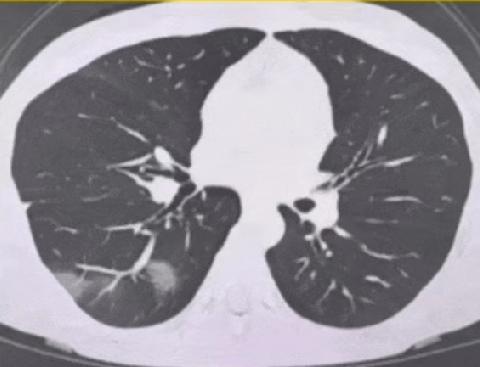

肌酐是肌肉代谢的产物,会通过肾脏排出体外,所以常被用来评估肾功能。 要是肌酐高,就意味着血液中肌酐水平超出正常范围,可能是肾脏功能不全的标志。原因有不少,肾脏疾病像急慢性肾炎、肾硬化等,会让肾脏排泄功能下降,肌酐排不出去;脱水、心衰或者用了某些药导致肾脏血流减少,也会让肌酐升高;大量运动、肌肉病变或者吃太多肉,会增加肌酐生成量。 肌酐高早期可能没啥症状,后面可能会乏力、没胃口、恶心呕吐。严重时会水电解质失衡、酸碱平衡异常,甚至发展成尿毒症。发现肌酐高,得赶紧查明原因,配合治疗,调整生活方式。



肌酐是肌肉代谢的产物,会通过肾脏排出体外,所以常被用来评估肾功能。 要是肌酐高,就意味着血液中肌酐水平超出正常范围,可能是肾脏功能不全的标志。原因有不少,肾脏疾病像急慢性肾炎、肾硬化等,会让肾脏排泄功能下降,肌酐排不出去;脱水、心衰或者用了某些药导致肾脏血流减少,也会让肌酐升高;大量运动、肌肉病变或者吃太多肉,会增加肌酐生成量。 肌酐高早期可能没啥症状,后面可能会乏力、没胃口、恶心呕吐。严重时会水电解质失衡、酸碱平衡异常,甚至发展成尿毒症。发现肌酐高,得赶紧查明原因,配合治疗,调整生活方式。

作者最新文章
热门分类
社会TOP
社会最新文章